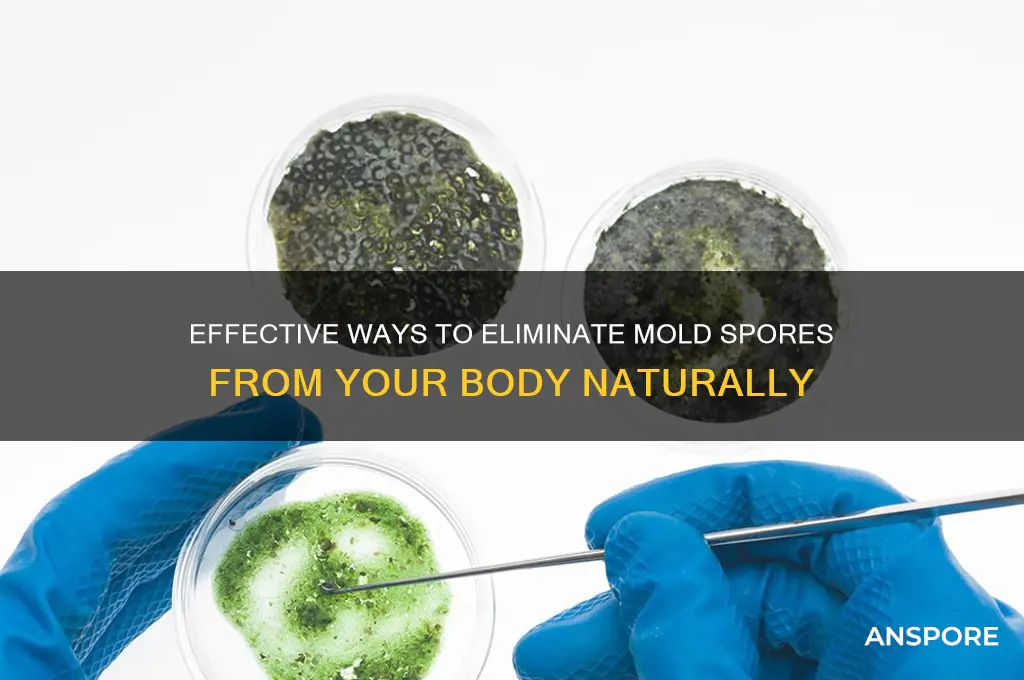
how to get rid of mold spores in body

Mold spores can enter the body through inhalation, ingestion, or skin contact, potentially leading to health issues such as allergies, respiratory problems, or infections, especially in individuals with weakened immune systems. Addressing mold exposure involves a two-fold approach: reducing environmental mold sources and supporting the body’s natural detoxification processes. To eliminate mold spores from the body, it’s essential to minimize exposure by identifying and remediating mold in living spaces, improving indoor air quality, and using air purifiers with HEPA filters. Simultaneously, strengthening the immune system through a balanced diet, staying hydrated, and incorporating antifungal foods or supplements like garlic, oregano oil, or probiotics can aid in clearing mold spores. Consulting a healthcare professional for targeted treatments or medications may also be necessary for severe cases.
| Characteristics | Values |
|---|---|
| Exposure Prevention | Avoid moldy environments, improve indoor air quality, use air purifiers with HEPA filters, fix water leaks promptly. |
| Dietary Support | Consume anti-fungal foods (garlic, oregano oil, coconut oil), increase probiotics (yogurt, kefir), stay hydrated, reduce sugar intake. |
| Detoxification Methods | Sweat through exercise or saunas, use binders like activated charcoal or bentonite clay, support liver function with milk thistle or dandelion root. |
| Supplements | Vitamin C, glutathione, NAC (N-acetylcysteine), zinc, and selenium to boost immune function and detoxification. |
| Medications | Antifungal medications (prescription or OTC) like fluconazole or nystatin, under medical supervision. |
| Immune Support | Adequate sleep, stress management, regular exercise, and a balanced diet to strengthen the immune system. |
| Symptom Management | Address respiratory issues with nasal rinses, use antifungal creams for skin infections, treat allergies with antihistamines. |
| Professional Guidance | Consult healthcare providers for testing (e.g., mycotoxin tests), personalized treatment plans, and monitoring progress. |
| Environmental Cleaning | Use mold-killing solutions (vinegar, hydrogen peroxide), clean HVAC systems, and remove mold-prone materials like carpet in damp areas. |
| Long-Term Maintenance | Regularly inspect for mold, maintain low humidity levels (<50%), and ensure proper ventilation in living spaces. |
What You'll Learn
- Boost Immune System: Eat healthy, exercise, and manage stress to strengthen immunity against mold toxins
- Detoxification Methods: Use binders like activated charcoal or zeolite to eliminate mold toxins from the body
- Anti-Fungal Supplements: Take natural antifungals like oregano oil or garlic to combat mold spores internally
- Hydration and Sweating: Drink water and use saunas to flush out toxins through sweat and urine
- Avoid Mold Exposure: Identify and remove mold sources in your environment to prevent recontamination

Boost Immune System: Eat healthy, exercise, and manage stress to strengthen immunity against mold toxins
Mold spores, once inhaled or ingested, can trigger inflammatory responses and weaken the body's defenses. A robust immune system acts as the first line of defense, neutralizing toxins and preventing mold-related illnesses. To fortify this defense mechanism, focus on three interconnected pillars: nutrition, physical activity, and stress management. Each plays a unique role in enhancing immune function, collectively creating a resilient barrier against mold toxins.
Nutrition: Fuel Your Immune System
A diet rich in antioxidants, vitamins, and minerals is essential for immune health. Incorporate foods high in vitamin C (citrus fruits, bell peppers), vitamin D (fatty fish, fortified dairy), and zinc (nuts, seeds, legumes) to support immune cell function. Probiotic-rich foods like yogurt, kefir, and fermented vegetables promote gut health, where 70% of immune cells reside. Aim for a daily intake of 7–9 servings of fruits and vegetables, prioritizing colorful varieties to maximize antioxidant benefits. Avoid processed foods and sugars, which can suppress immune responses and exacerbate inflammation.
Exercise: Activate Immune Vigilance
Regular physical activity stimulates the circulation of immune cells, improving their ability to detect and eliminate toxins. Aim for at least 150 minutes of moderate exercise (brisk walking, cycling) or 75 minutes of vigorous activity (running, HIIT) weekly. For older adults or those with chronic conditions, low-impact exercises like swimming or yoga can be equally effective. Caution: Over-exercising can stress the body, so balance intensity with rest days. Post-exercise hydration and a protein-rich snack aid recovery and immune function.
Stress Management: Calm the Immune Response
Chronic stress releases cortisol, which suppresses immune activity and increases susceptibility to mold-related illnesses. Practices like mindfulness meditation, deep breathing exercises, or progressive muscle relaxation can reduce stress levels. Allocate 10–20 minutes daily to these activities, especially during high-stress periods. Adequate sleep (7–9 hours per night) is equally critical, as it allows the body to repair and regenerate immune cells. For those struggling with stress, consider consulting a therapist or integrating adaptogenic herbs like ashwagandha (300–500 mg daily) under professional guidance.
Synergy for Optimal Immunity
While each pillar strengthens immunity independently, their combined effect is exponentially greater. For instance, a balanced diet fuels the energy required for exercise, which in turn reduces stress hormones. Conversely, neglecting one area can undermine progress in others. Start with small, sustainable changes—swap sugary snacks for berries, take a 10-minute walk daily, or practice gratitude journaling before bed. Over time, these habits create a holistic immune-boosting lifestyle, empowering the body to combat mold toxins effectively.
Do Only Select Bacilli Species Produce Spores? Exploring Bacterial Diversity
You may want to see also

Detoxification Methods: Use binders like activated charcoal or zeolite to eliminate mold toxins from the body
Mold exposure can lead to a buildup of mycotoxins in the body, causing symptoms like fatigue, brain fog, and respiratory issues. Detoxification methods aim to eliminate these toxins, and binders like activated charcoal and zeolite are emerging as effective tools. These substances act like magnets, attracting and binding to toxins in the gut before they can be absorbed into the bloodstream. This process, known as adsorption, prevents toxins from recirculating and supports their safe elimination through bowel movements.
Activated charcoal, derived from coconut shells or wood, has a long history of use in emergency medicine for poisoning. For mold toxin removal, it’s typically taken in capsule form, with dosages ranging from 500 mg to 2,000 mg per day, depending on severity of exposure. It’s crucial to take charcoal on an empty stomach, at least two hours away from meals or medications, to avoid interfering with nutrient absorption. Zeolite, a mineral with a honeycomb-like structure, works similarly but has a higher affinity for positively charged toxins. Clinoptilolite, a specific type of zeolite, is often recommended for mold detoxification, with dosages starting at 5 grams daily, gradually increasing as tolerated.
While both binders are generally safe, they come with caveats. Activated charcoal can cause constipation or black stools, and zeolite may deplete electrolytes if not paired with a mineral-rich diet. Pregnant or breastfeeding individuals should avoid these supplements due to limited safety data. Additionally, long-term use without professional guidance can lead to unintended consequences, such as nutrient deficiencies. Always consult a healthcare provider before starting a binder regimen, especially if you have underlying health conditions.
Comparing the two, activated charcoal is more accessible and affordable, making it a popular choice for acute mold exposure. Zeolite, however, is favored for its broader toxin-binding capabilities and gentler effect on the gut. Combining both under expert supervision can maximize detoxification while minimizing side effects. For instance, starting with charcoal to address immediate toxin load, followed by zeolite for sustained support, is a strategy some practitioners recommend.
Practical tips for optimizing binder effectiveness include staying hydrated to aid toxin elimination and incorporating gut-healing foods like bone broth or fermented vegetables. Monitoring symptoms and adjusting dosages based on response is key. While binders are powerful tools, they’re most effective as part of a comprehensive mold detoxification plan that includes mold avoidance, dietary changes, and liver support. Used correctly, activated charcoal and zeolite can be game-changers in reclaiming health from mold-related toxicity.
Growing Your Spore Flock: Tips for Adding New Creatures Effectively
You may want to see also

Anti-Fungal Supplements: Take natural antifungals like oregano oil or garlic to combat mold spores internally
Mold exposure can lead to systemic inflammation and persistent symptoms, even after environmental remediation. Natural antifungals like oregano oil and garlic offer a targeted approach to combating mold spores internally, addressing both active infections and residual toxins. Oregano oil, rich in carvacrol, has been shown to inhibit fungal growth and disrupt biofilms, making it a potent ally against mold-related issues. Garlic, with its active compound allicin, not only exhibits antifungal properties but also supports immune function, aiding the body’s natural defenses.
To incorporate oregano oil into your regimen, start with a low dose—1–2 drops diluted in a carrier oil or capsule form daily—gradually increasing to 4–6 drops as tolerated. For garlic, aim for 2–4 cloves daily, either raw, cooked, or in supplement form (600–1,200 mg of aged garlic extract). Children and those with sensitive digestive systems should begin with half the adult dose, monitoring for any adverse reactions. Consistency is key; these supplements work best when taken regularly over several weeks to months, depending on the severity of exposure.
While oregano oil and garlic are generally safe, they are not without cautions. Oregano oil can irritate the stomach lining if taken undiluted or in excessive amounts, and garlic may interact with blood thinners or cause digestive discomfort in some individuals. Pregnant or breastfeeding women should consult a healthcare provider before starting any new supplement regimen. Pairing these antifungals with a low-sugar, anti-inflammatory diet enhances their efficacy, as mold thrives on sugar and refined carbohydrates.
The comparative advantage of natural antifungals lies in their dual action: they not only target mold spores but also support overall health without the systemic side effects often associated with pharmaceutical antifungals. Unlike prescription medications, which can disrupt gut flora, oregano oil and garlic promote a balanced microbiome when used appropriately. This makes them particularly appealing for long-term use or as part of a holistic mold recovery plan.
Incorporating these supplements into your routine requires patience and mindfulness. Track your symptoms weekly to gauge progress, and consider rotating antifungals every 2–3 months to prevent tolerance. For example, alternate between oregano oil and garlic or combine them with other natural antifungals like caprylic acid or grapefruit seed extract. Practical tips include taking oregano oil with meals to minimize stomach upset and consuming garlic with vitamin C-rich foods to enhance allicin absorption. By leveraging these natural tools, you can proactively address mold spores internally and restore balance to your body.
How Long Do Mold Spores Survive? Understanding Their Lifespan and Eradication
You may want to see also

Hydration and Sweating: Drink water and use saunas to flush out toxins through sweat and urine
Mold spores, once inhaled or ingested, can linger in the body, potentially causing systemic inflammation and toxicity. One effective strategy to expel these unwanted invaders is through hydration and sweating, leveraging the body’s natural detoxification pathways: sweat and urine. Drinking ample water—aim for 3 to 4 liters daily—dilutes toxins in the bloodstream, making it easier for the kidneys to filter them out via urine. Simultaneously, sweating in a sauna or through exercise opens another exit route, as mold toxins can be excreted through the skin.
Consider this: saunas elevate core body temperature, mimicking a fever-like state that stimulates the immune system and enhances detoxification. For optimal results, spend 15–20 minutes in a sauna 3–4 times per week, ensuring you rehydrate immediately afterward to replace lost fluids. If saunas aren’t accessible, vigorous exercise like running, cycling, or high-intensity interval training (HIIT) can induce sweating and achieve similar benefits. Pairing these activities with proper hydration amplifies their detoxifying effects, creating a one-two punch against mold toxins.
However, not all sweating is created equal. Passive sweating, such as from wearing plastic sweat suits or sitting in a hot car, doesn’t provide the same detox benefits as active sweating from exercise or sauna use. The key is to increase circulation and metabolic rate, which mobilizes toxins stored in fat cells and allows them to be expelled. For those with mold sensitivity or chronic illnesses, start slowly—perhaps 10 minutes in a sauna or 20 minutes of light exercise—and gradually increase duration as tolerance improves.
A cautionary note: overhydration, while rare, can lead to hyponatremia, a dangerous drop in blood sodium levels. To avoid this, balance water intake with electrolyte-rich foods like bananas, spinach, or coconut water, especially after sweating profusely. Additionally, individuals with cardiovascular conditions or those pregnant should consult a healthcare provider before using saunas or engaging in intense physical activity.
In practice, combine hydration and sweating with other mold-detox strategies, such as a low-mold diet and binders like activated charcoal or bentonite clay, for a comprehensive approach. Think of hydration and sweating as the body’s internal car wash—rinsing away toxins and leaving systems refreshed. By prioritizing these simple yet powerful tools, you can support your body’s natural ability to eliminate mold spores and restore balance.
Effective Methods to Eliminate Shotgun Mold Spores on Vinyl Siding
You may want to see also

Avoid Mold Exposure: Identify and remove mold sources in your environment to prevent recontamination
Mold spores are ubiquitous, but their presence in your environment can lead to persistent health issues, especially if they find their way into your body. The first line of defense against mold-related health problems is to prevent exposure by identifying and eliminating mold sources in your surroundings. This proactive approach not only safeguards your health but also prevents recontamination, breaking the cycle of mold-related illnesses.
Identifying Hidden Mold Sources
Mold thrives in damp, humid environments, often hiding in places you might overlook. Common culprits include leaky pipes, poorly ventilated bathrooms, basements, and even houseplants with overly moist soil. Use a flashlight to inspect dark corners, check for musty odors, and monitor areas prone to moisture buildup. Professional mold testing kits or inspectors can provide definitive answers if you suspect hidden mold. For instance, a hygrometer can measure humidity levels; readings above 60% indicate conditions ripe for mold growth. Addressing these issues promptly is crucial, as prolonged exposure to mold spores can lead to respiratory problems, allergies, and other systemic issues.
Step-by-Step Mold Removal
Once identified, mold must be removed safely and thoroughly. For small areas (less than 10 square feet), you can handle the cleanup yourself. Wear protective gear, including gloves, goggles, and an N95 mask, to avoid inhaling spores. Scrub affected surfaces with a mixture of water and detergent, then dry the area completely. For larger infestations, hire professionals to ensure complete eradication. Porous materials like drywall or carpet may need to be discarded, as mold can penetrate deeply. After removal, use a HEPA vacuum to clean the area and prevent spores from spreading. Remember, improper removal can exacerbate the problem, so follow EPA guidelines for safe mold remediation.
Preventing Recontamination
Eliminating mold is only half the battle; preventing its return is equally critical. Start by fixing the root cause of moisture, such as repairing leaks or improving ventilation. Dehumidifiers can help maintain indoor humidity below 50%, creating an environment less hospitable to mold. Regularly clean areas prone to moisture, like shower tiles and refrigerator drip pans. For ongoing protection, consider using mold-resistant products like paints and sealants in high-risk areas. Additionally, monitor indoor plants and ensure proper drainage to avoid excess moisture. These measures not only prevent mold regrowth but also contribute to a healthier living space.
Practical Tips for Daily Prevention
Incorporate mold prevention into your daily routine to minimize exposure. Wipe down wet surfaces immediately, especially in kitchens and bathrooms. Use exhaust fans during cooking, showering, or laundering to reduce humidity. Store firewood and other organic materials away from your home, as they can harbor mold spores. If you live in a humid climate, run a dehumidifier regularly and empty the collection tray to prevent it from becoming a mold source itself. For individuals with mold sensitivities, consider using air purifiers with HEPA filters to capture airborne spores. Small, consistent actions can make a significant difference in maintaining a mold-free environment.
By identifying and removing mold sources, you not only protect your immediate health but also create a sustainable living environment that resists recontamination. This proactive approach is essential for anyone looking to eliminate mold spores from their body, as it addresses the problem at its source. With vigilance and the right strategies, you can break the cycle of mold exposure and enjoy a healthier, mold-free life.
Exploring Sexual Reproduction in Fungal Spores: A Comprehensive Overview
You may want to see also
Frequently asked questions
Symptoms of mold exposure can include respiratory issues (coughing, wheezing), nasal congestion, skin irritation, headaches, fatigue, and in severe cases, asthma attacks or allergic reactions.
Mold spores can enter the body through inhalation, ingestion, or skin contact. They are commonly found in the air, on surfaces, or in contaminated food or water.
Mold spores typically do not grow inside the body because the environment is not suitable for their growth. However, they can cause infections in individuals with weakened immune systems.
To detox from mold exposure, focus on improving indoor air quality, staying hydrated, eating an anti-inflammatory diet, and supporting your immune system with vitamins like C and D. Consult a healthcare professional for personalized advice.
Treatment depends on the severity of exposure. It may include antifungal medications, nasal sprays, allergy medications, or immunotherapy. Addressing the source of mold in your environment is also crucial.

